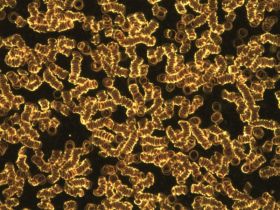
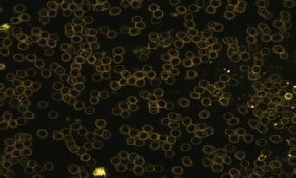

Seminare
DAN Energie
DAN Energie Level 1
DAN Energie Level 2
DAN Energie Level 3
DANsin
Blütentropfen
Workshop
Webinare
Kontakt

Angebote
News
Massagen
DAN-Behandlungen
Seminare/Workshop
Kontakt
Nahrungsoptimierung
DAN-Produkte
Philosophie
animalDAN
über mich